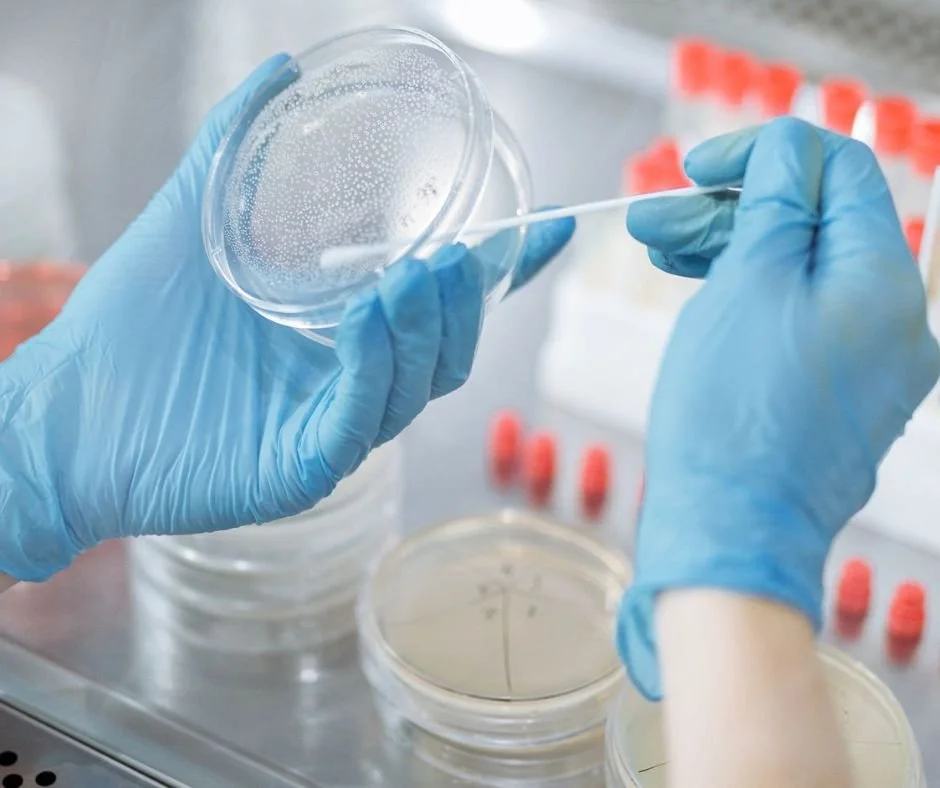

Worried about a Legionella outbreak in your business? Discover MSE Environmental's strategic cost-benefit analysis of their proven regular Legionella testing. Embrace the advantages of cost-benefit analysis in healthcare to prevent costly legionnaires’ disease lawsuits and secure advanced health and safety.
Understanding the cost of Legionella testing and the added cost of testing can transform your approach to water safety. In Dallas Texas Legionella testing solutions, including the Legionella PCR test, ensure you know how to prevent a Legionella outbreak effectively and economically.
Understanding the Costs of Regular Legionella Testing
Why do we need to test for Legionella? The answer is simple: safety and compliance. If left unchecked, Legionella bacteria can develop in water systems and present a serious health danger. Regular testing is our best defense, ensuring these systems are safe for everyone.
Why Test for Legionella?
Regular testing identifies the presence of Legionella and helps prevent its growth before it becomes a problem. MSE Environmental uses top-notch Legionella testing solutions to spot signs of this dangerous bacterium. Our water testing for Legionella is a thorough process that checks every nook and cranny of your water system.
Why is Routine Monitoring Important?
Routine monitoring plays a crucial role in managing and controlling the risks associated with Legionella bacteria. It’s not just about testing once and forgetting about it; it's about regular checks to ensure ongoing safety. This continuous vigilance helps prevent the growth of Legionella, safeguarding the health of individuals and the operational standards of facilities. By catching issues early, we can tackle them before they escalate into more severe problems.
Breakdown of Legionella Testing Costs
Understanding the costs of regular Legionella testing is critical for any facility manager or business owner. Let's break down the expenses to see why investing in this proactive step is necessary and wise.
Sample Collection
The first step in the process is sample collection. Trained professionals visit your site to collect water samples from various points within your water system. This step is crucial because sample quality determines test accuracy. Each sample must be handled with care and sterile techniques to avoid contamination. Contamination could naturally affect the outcome of the test.
Laboratory Analysis
Once the samples are collected, they undergo laboratory analysis. Here, the focus is on the Legionella PCR test, a sophisticated method that detects the DNA of Legionella bacteria. This test is susceptible and can quickly determine the presence of the bacteria, which is essential for timely intervention. The cost of Legionella testing largely depends on the frequency of testing and the number of locations sampled. However, investing in accurate and reliable PCR testing can save on potential future outbreak costs.
Consultation and Action
After the lab results are in, the next step involves consultation and action. Based on the findings, experts guide the necessary measures to control or eliminate the risk. This might include adjusting water temperatures, flushing systems, or more extensive remedial actions depending on the severity of the contamination. The added cost of testing consists of these expert consultations. They are vital for effective water system management and ensuring compliance with health regulations.
Each step involves costs but significantly less than the potential expenses and consequences of a Legionella outbreak. Investing in regular testing is a wise and economical choice.
The Financial Risks of a Legionella Outbreak
The financial implications of a Legionella outbreak can be severe and far-reaching. Understanding these risks highlights the importance of preventive measures like regular Legionella testing.
What Happens During a Legionella Risk Assessment?
A Legionella risk assessment thoroughly evaluates your water system to identify any Legionella-promoting conditions. This process includes inspecting water temperatures, storage facilities, and potential contamination points. Experts analyze how water is used and stored, ensuring that no environment within the system supports bacteria proliferation.
Consequences If Legionella Is Detected in Water
If Legionella is detected, immediate action is required to mitigate the risk and prevent an outbreak. This involves not only treating the water system but also notifying authorities and potentially affected individuals. The phrase "what happens if Legionella is detected in water" triggers mandatory responses to control the situation swiftly and effectively.
Potential Financial Impacts
The costs associated with a Legionella outbreak can be substantial:
Healthcare Costs: Treatment for Legionnaires' disease can be extensive, involving hospitalization and long-term care, which incurs significant healthcare costs.
Legal Liabilities: Facilities found negligent in managing Legionella risks may face "Legionnaires disease lawsuit," leading to hefty legal fees and settlements. This aspect alone can be financially debilitating for businesses.
Reputation Damage: An outbreak can severely damage a business's reputation. Loss of trust from customers and clients can lead to a decline in business, affecting financial stability.
Regulatory Fines: Non-compliance with health and safety regulations can result in substantial fines from bodies like OSHA and the EPA. These fines are financial burdens and serve as public records of non-compliance, further affecting a company's image.
Understanding these risks and potential financial impacts reinforces why MSE Environmental emphasizes the importance of regular Legionella outbreak prevention measures. The cost of proactive testing is minimal compared to an outbreak's potential financial and human costs.
The Benefits of Regular Testing With MSE Environmental
Choosing MSE Environmental for regular Legionella testing offers numerous advantages. These benefits protect public health and provide significant economic value, showcasing the clear advantages of cost-benefit analysis in healthcare.
Prevention of Disease Through Early Detection
One of the main advantages of regular testing is disease prevention through early detection of Legionella. By identifying the presence of the bacteria before it leads to an outbreak, necessary preventive measures can be promptly implemented. This proactive stance greatly reduces the risk of disease transmission, ensuring the safety and health of all building occupants.
Compliance with Regulations
Regular testing helps ensure compliance with local and national health regulations. Many regions have stringent guidelines regarding water system maintenance to prevent the growth of Legionella. Staying compliant not only avoids legal issues but also reinforces a business's commitment to health and safety standards. This compliance is a crucial aspect of the cost-benefit analysis in healthcare. It helps mitigate potential legal and regulatory penalties.
Cost Savings by Preventing Outbreaks
Managing a Legionella outbreak can be substantial, encompassing treatment costs, legal fees, potential fines, and more. Regular testing significantly reduces these potential costs by preventing outbreaks before they happen. Understanding how to prevent a Legionella outbreak and implementing these measures can lead to considerable financial savings. Instead of dealing with the consequences of an outbreak, businesses can invest in MSE Envionemental’s regular and effective Legionella testing.
MSE Environmental protects public health and helps businesses manage their budgets by lowering risk and guaranteeing compliance.
MSE Environmental’s Testing Process for Legionella
MSE Environmental's approach to Legionella testing is thorough, ensuring every aspect of testing is covered, from sample collection to consultation. Our methods are built on advanced health and safety protocols, offering an effective Legionella outbreak solution.
Sampling
The first step in our process is sampling. Our trained technicians collect samples from various parts of your water systems. This includes, but is not limited to, cooling towers, hot water tanks, and other potential risk areas. We use sterile equipment and careful protocols to ensure these samples accurately represent your system’s water quality and conditions.
Testing Methods
Once collected, samples are tested using the latest, regulated testing methods. MSE Environmental employs traditional culture methods and advanced molecular techniques like the Legionella PCR test. This combination ensures high accuracy and the ability to detect Legionella bacteria efficiently, providing a reliable basis for further actions.
Reporting
After testing, MSE Environmental provides detailed reports on the findings. These reports are clear and comprehensive, outlining the results and what they mean for your facility. We ensure you understand every aspect of the report so you can make informed decisions about any necessary actions.
Consultation
Beyond testing and reporting, MSE Environmental offers expert consultation. If Legionella is detected, our specialists work closely with you to develop a tailored prevention and remediation plan. This might include recommendations for water system adjustments, temperature controls, and other management practices that help mitigate Legionella outbreak risk.
Through careful testing, MSE Environmental ensures your facilities are safe, compliant, and Legionella-free. Our proactive approach prevents health risks and positions your business as a leader in health and safety.
What have we learned?
At MSE Environmental, we understand that a cost-benefit analysis is crucial in making informed health and safety measures decisions. Regular Legionella testing is the best prevention. The small upfront cost of regular testing significantly outweighs the potentially high costs and risks associated with a Legionella outbreak.
By being proactive, facilities comply with health regulations and avoid the financial drain and reputational harm an outbreak could cause. What is the cost-benefit analysis of regular Legionella testing? It's simple: investing a little today can save a lot tomorrow—not just in money but in health outcomes and business integrity.
By partnering with MSE Environmental, you can rest assured that your building's water quality is in good hands. Our team of experts is dedicated to providing top-notch service, ensuring that your building's occupants can enjoy a safe and healthy environment. Contact us today to learn more about how we can help you achieve your building health goals.
Why wait for a crisis? Ensure your facility's health and secure your business reputation by scheduling a Legionella test with MSE Environmental. For detailed information or to book our services, contact us at (888)258-3860 or info@msenational.com. Protect your facility today—because safety can't wait!

Discover how MSE Environmental ensures Legionella testing in hospitals and healthcare facilities. Protect your environment with our expert risk management services.